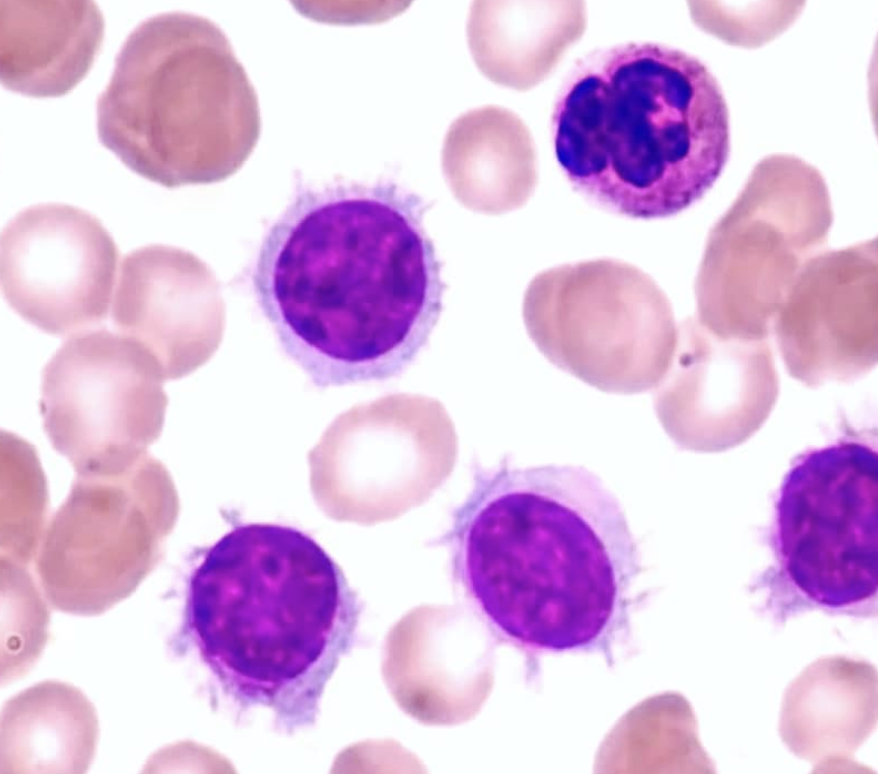

1
Q
Célula proliferante característica.
A
Linfocito B maduro “peludo”.
2
Q
¿Mutación clásica en HCL?
A
Mutación BRAF V600E
≈ 90% de los casos
3
Q
¿Qué produce la mutación BRAF V600E?
A
Activación constitutiva de la vía MAPK, → proliferación de células B
4
Q
Tinción diagnóstica clásica.
A
TRAP positiva
Fosfatasa ácida resistente al tartrato (TRAP) positiva
5
Q
Hallazgos característicos.
A
Esplenomegalia masiva + pancitopenia + infecciones recurrentes
Infecciones por micobacterias atipicas (listeria)
6
Q
¿Por qué hay pancitopenia en HCL?
A
Infiltración medular difusa + fibrosis → médula “seca” (dry tap)
7
Q
¿Hay adenopatías?
A
No.
8
Q
Tratamiento gold standard.
A
Cladribina (2-CDA)
(🚫ADA)
9
Q
- Principal diagnóstico diferencial de HCL:
- ¿Cuál es la diferencia?
A
- HCL variante (HCL-v).
- HCL-v: NO expresa CD25


